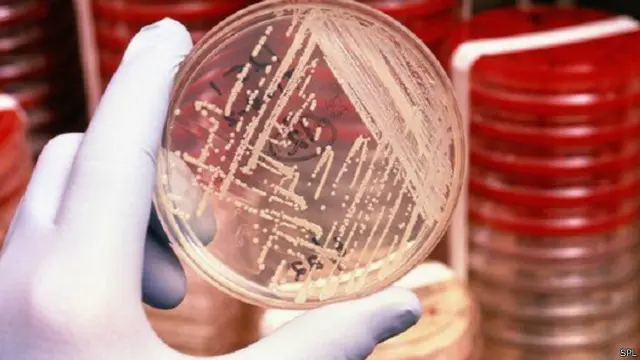
أحد المضادات الجديدة أثبت فاعليته في مواجهة أمراض السل وبكتيريا المكورات العنقودية

دعوات لإنشاء صندوق أبحاث عالمي للمضادات الحيوية بملياري دولار

صدر الصورة، SPL
- Author, فيرغاس وولش
- Role, مراسل الشؤون الطبية
ناشدت لجنة حكومية بريطانية مؤسسات صناعة الدواء العالمية تقديم ملياري دولار لتأسيس صندوق إبتكار لتحفيز الأبحاث في مجال المضادات الحيوية.
وفي المقابل ستكون هناك ضمانات لتقديم أموال للشركات التي ستنتج مضادات جديدة مطلوبة بشدة.
وهناك حاليا عدد قليل جدا من المضادات الحيوية الجديدة قيد التطوير وسط انتشار للبكتريا المقاومة للمضادات على مستوى العالم.
وجاءت هذه المقترحات في تقرير أعدته لجنة مراجعة عينتها الحكومة البريطانية برئاسة الخبير الاقتصادي جيم اونيل.
وقال اونيل: "نريد أن نبدأ تطوير عقاقير للتأكد من أن العالم يمتلك العقاقير التي يحتاجها لعلاج العدوى ومساعدة الطب الحديث والجراحة من مواصلة عملها بالطريقة التي نعهدها."
وكان اونيل حذر سابقا من أن الميكروبات المقاومة للعقاقير يمكن أن تودي بحياة عشرة ملايين شخص سنويا بحلول عام 2050 وتسبب خسائر اقتصادية بقيمة 100 مليار دولار.
وبدأت تنتشر أنواع البكتريا المقاومة للمضادات على مستوى العالم، وهو ما يهدد بفقدان الأدوية الحالية فاعليتها.
وسيستخدم صندوق الإبتكار العالمي المقترح بقيمة ملياري دولار على مدى خمس سنوات في تعزيز التمويل للأبحاث النظرية في مجال الأدوية والتشخيص، وسيوجه معظم المال إلى الجامعات والشركات الصغيرة لإنتاج المضادات الحيوية.
وأحد مجالات البحث الواعدة تتعلق بما يطلق عليها "مكونات تفتيت المقاومة"، وهي المكونات التي تعمل على تعزيز فاعلية المضادات الحيوية الحالية، وهو نهج أقل تكلفة بكثير من محاولات اكتشاف أدوية جديدة تماما.
وابتكرت شركة هيلبرباي ثيرابيوتيكس Helperby Therapeutics، التي أسسها البروفيسور انتوني كوتس الأستاذ بجامعة لندن، أحد العقاقير التي تعمل على تفتيت مقاومة المضادات، والذي ينشط في مواجهة بكتيريا المكورات العنقودية "إم، آر، إس، إي" MRSA شديدة المناعة للمضادات الحيوية.
وستبدأ في الهند قريبا التجارب السريرية لهذا العقار الذي يحمل اسم "اتش تي 61"، والذي جرى تطويره بموجب ترخيص منحته شركة كاديلا فارامسيوتيكالز انديا الهندية.
وقال فريق المراجعة البريطاني إن هذا النوع من الأبحاث يمكن أن يستفيد من صندوق الابتكار وقد يكون الوسيلة لجعل العقاقير الحالية تدوم لفترة أطول.
وقال أونيل إن شركات الأدوية الكبرى يجب عليها أن تدفع للصندوق وأن تتجاوز النظرة قصيرة الأمد لتقييمات الربح والخسارة.
وعقد أونيل، الذي شغل سابقا منصب كبير الاقتصاديين في بنك غولدمان ساكس الاستثماري، مقارنة بين الأزمة المصرفية والكارثة التي تلوح في الأفق إذا أصبح العالم خاليا من مضادات حيوية فعالة.
تمويل الابتكار
وأوضح اونيل أن شركات الأدوية بحاجة إلى التصرف من واقع "المصلحة الذاتية المستنيرة" لأنه "إذا ساءت الأمور بالفعل، فإن الناس سيجدون الفرصة لتوجيه الانتقادات الشديدة لهذه الشركات مثلما فعلوا في القطاع المالي" بسبب الأزمة المصرفية.
صدر الصورة، SPL
وجاءت تصريحات أونيل لبرنامج بانوراما على تلفزيون بي بي سي، والذي قضى ستة أشهر يتابع أنشطة فريق المراجعة، وقام بالتصوير في الهند والولايات المتحدة وبريطانيا.
وعين رئيس الوزراء البريطاني ديفيد كاميرون أونيل رئيسا للجنة المراجعة الخاصة بالنظر في مقاومة المضادات الحيوية، والتي تحصد أرواح ما يقدر بـ30 ألف شخص سنويا في أنحاء أوروبا.
وانسحبت العديد من الشركات من مجال الأبحاث في المضادات الحيوية.
وقال تقرير لجنة المراجعة إن هذا يعود جزئيا إلى الغموض بشأن الإيرادات التجارية للمضادات الحيوية الجديدة.
وبهدف تحفيز تطوير عقاقير جديدة، أكد فريق البحث ضرورة دفع مبالغ مالية لمرة واحدة للشركات التي تنتج مضادات حيوية جديدة يثبت فاعليتها.
وهذا من شأنه أن يكسر الصلة بين مستوى ربحية العقار وحجم مبيعاته.
ويتوقع فريق البحث أن مقترحاته قد تؤدي إلى إنتاج 15 مضادا حيويا جديدا خلال عقد من الزمن، من بينه أربعة على الأقل من المفترض أنها ستكون "منتجات تمثل اختراقا" تستهدف أنواع البكتريا التي تمثل أكبر تهديد.
اختراق أمريكي
لقد مر 30 عاما تقريبا منذ طرح سلسلة جديدة من المضادات الحيوية، أي مجموعة من العقاقير التي تحدث فاعلية جديدة بالفعل مقارنة بغيرها من العقاقير السابقة.
لكن هذه الفترة الفاصلة التي استمرت عقودا قد تكون انتهت بفضل اختراق أعلنه مؤخرا علماء أمريكيون، فقد اكتشف فريق من جامعة نورث ايسترن في بوسطن بولاية ماساشوستس 25 مضادا حيويا جديدا فعالا، وجميعها مشتقة من ميكروبات التربة.
وأحد هذه المضادات هو "تيكسوباكتن" الذي أثبت فاعليته في مواجهة السل و بكتيريا المكورات العنقودية .
وهذا العقار من إنتاج شركة نوفو بيوتك فارماسيوتيكالز ومن المقرر أن يدخل مرحلة التجارب السريرية في غضون أسبوعين.
وقال البروفيسور كيم لويس من جامعة نورث ايسترن وأحد مؤسسي الشركة لبرنامج بانوراما: "أعتقد أنه قد يكون هناك آلاف أخرى من المضادات الحيوية في التربة لم تكتشف بعد."
وأضاف بأنه لا يزال هناك الكثير من حالات الغموض.








